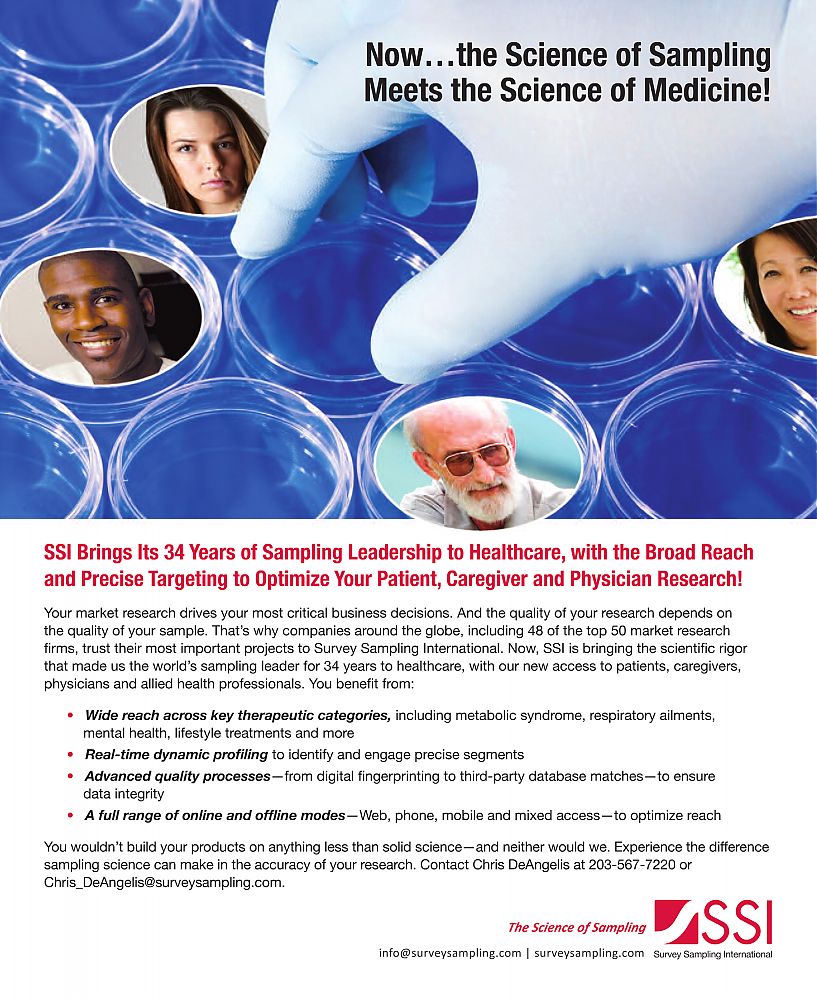
Survey_Sampling_International-SSI-PharmaVoice-February2011.jpg

| Keyword(s) - "_SSI_brand" | |||||
|
|
||||
|
|||||
|
|
|||||
-
×
Member Login
You don't have a user name and password?
Get full 24/7 access to the gallery.
Click here to subscribe.

 SSI - Obsessed with accessing
SSI - Obsessed with accessing